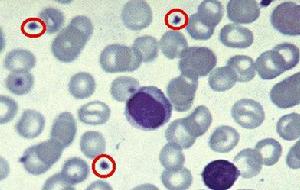
骨髓病性貧血
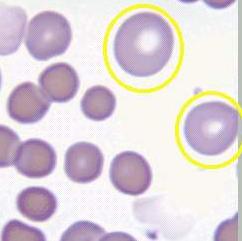
骨髓病性貧血

概述
血小板
血小板診斷依據
1.大多數呈正細胞性貧血,可伴有白細胞及血小板減少。 2.血塗片可見明顯的紅細胞大小不等和異形紅細胞增多。血片中可見幼稚粒細胞和幼稚紅細胞。 3.骨髓塗片和活檢可發現原發疾病的表現。癌腫轉移者可在片尾找到成團出現的癌細胞。 4.X線骨骼攝片,放射性核素掃描可發現腫瘤骨骼轉移病源。
治療原則
1.控制原發病。 2.嚴重貧血時輸注紅細胞。 3.支援療法。
療效評價
好轉:原發病得到緩解,貧血症狀減輕。 無效:原發病和貧血症狀無變化或進一步加重。
專家提示
本病不是單獨的一個疾病,而是一組疾病的臨床表現。由於病因不同,故其治療應針對原發病。本病治療效果不理想。特別對於腫瘤引起骨髓浸潤,治癒的希望是極微的。
病因
1.轉移癌甲狀腺癌、胃癌、結腸直腸癌、肺癌、肝癌、乳癌腎癌、前列腺癌、神經母細胞瘤,幾乎所有癌腫都可轉移至骨髓。
2.造血系統腫瘤①幹細胞疾病:急性髓系白血病、慢性粒細胞白血病、真性紅細胞增多症、原發性骨髓纖維化;②非幹細胞疾病:急性淋巴細胞白血病、慢性淋巴細胞白血病、多發性骨髓瘤惡性組織細胞病、惡性淋巴瘤等。
3.感染、炎症細菌性(結核菌、葡萄球菌、傷寒菌等)、真菌(組織胞漿菌)等。
4.代謝性疾病單核吞噬細胞系統儲積病(Gaucher病)、單核吞噬系統遺傳性缺陷病(骨硬化症)等。
發病機制
 幼粒幼紅細胞
幼粒幼紅細胞1.骨髓受腫瘤或異常組織的浸潤骨髓微環境遭受破壞,導致正常造血功能受損,發生貧血。因骨髓-血液屏障(bonemarrow-bloodbarrier)受破壞出現幼粒幼紅細胞血象。
2.髓外造血骨髓被侵犯後,體內可能發生代償性髓外造血因某種因素使癌症患者EPO產生增多也可激發髓外造血,主要場所是脾臟、肝臟和淋巴結。髓外造血缺乏屏障出現幼粒幼紅細胞血象脾臟腫大繼發脾功能亢進時引起全血細胞減少。
3.轉移癌在骨髓中形成浸潤灶或發生骨髓壞死其周圍造血組織可能增生不良並可被纖維組織代替,這可能因為腫瘤細胞釋放造血抑制物及纖維母細胞生長因子所致。
4.紅細胞無效生成、並發微血管病性溶血性貧血產生自身免疫性抗體致使紅細胞壽命縮短,破壞增加。由於鐵利用不良可出現鐵粒幼細胞貧血,但較少見。
5.失血消化道腫瘤、宮頸癌容易合併出血,引起失血;腫瘤組織釋放凝血活酶,發生血栓形成而引起DIC亦為出血的原因。
6.營養缺乏腫瘤患者食慾減退,胃酸缺乏使葉酸缺乏,蛋白質缺乏。腫瘤及毒素抑制造血,干擾鐵、蛋白質葉酸、維生素B12的正常利用。
7.放療、化療、嚴重感染抑制造血功能。
臨床表現
1.症狀和體徵
(1)原發疾病的症狀與體徵:常因原發疾病的症狀突出而掩蓋繼發性貧血的表現,也可能以貧血及骨痛為首發症狀而缺乏原發疾病的臨床表現。
(2)貧血是重要常見症狀:輕重不一進行性加重,貧血程度與腫瘤大小範圍及骨髓浸潤程度無明顯相關用葉酸、鐵劑、維生素B12等治療無效,合併感染可以加重貧血程度。
(3)髓外造血的表現肝、脾淋巴結腫大。
(4)出血傾向:血小板減少,或伴有DIC時鶒,可有不同程度的出血現象。
(5)骨痛:一個部位或多部位骨痛,如腰痛可伴局部隆起、壓痛甚至有病理性骨折,骨髓壞死時會有劇烈的疼痛,也可伴有心律不齊、多尿、噁心嘔吐、腹痛腹瀉甚至昏迷等。
診斷
診斷要點:
1.有引起骨髓浸潤性貧血的原發疾病。
2.一處及多處骨痛骨質破壞及高鈣血症相的症狀和體徵
3.貧血伴無確切原因可解釋的肝脾腫大。
4.幼粒幼紅細胞血象。
5.骨髓代償性活躍或“乾抽”,骨髓穿刺或活檢找到轉移瘤細胞
6.X線檢查示骨質破壞
鑑別診斷
網織紅細胞
網織紅細胞2.慢性粒細胞白血病(CML)有巨大脾臟,白細胞計數顯著增高嗜酸及嗜鹼性粒細胞增多;中性鹼性磷酸酶(NAP)活性減低甚至為零,Ph染色體陽性。
3.缺鐵性貧血(IDA)惡性腫瘤轉移至骨髓而原發病灶不明顯時可誤診為IDA。對未能找到缺鐵性貧血的病因和缺鐵實驗室檢查依據的小細胞低色素性貧血,或用鐵劑治療僅能收到暫時效果者應仔細尋找原發病灶。
4.溶血性貧血有紅細胞破壞增多和骨髓代償性增生的證據,網織紅細胞增加,且紅細胞變化明顯而無粒細胞和血小板改變。也無骨痛、骨質破壞等表現。
5.再生障礙性貧血無骨痛及肝、脾淋巴結腫大;無幼粒幼紅細胞血象;骨髓增生低下,非造血細胞增加,無骨質破壞,無腫瘤細胞浸潤。
6.MDS一般無肝脾淋巴結腫大,有異常病態造血的形態學特點。
7.骨髓浸潤性貧血並非僅見於惡性腫瘤,還可見於嚴重感染炎症、脂質儲積病等;幼粒幼紅細胞血症也可見於重度失血、短暫缺氧、急性感染等原因所致的骨髓壞死等,在鑑別診斷時,需要十分注意鑑別。
治療
1.治療原發疾病為主但此類病人需用化療時一般要用常規劑量的1/2~1/3比較安全,以避免骨髓受到嚴重抑制。
2.支持治療貧血嚴重及血小板減少並伴有出血傾向時適當輸血及輸注血小板鐵劑、葉酸、維生素B12、補血藥一般無效
3.雄激素、腎上腺皮質激素骨髓纖維化時可試用。
4.脾切除出現巨脾脾功能亢進成為全血細胞減少的重要原因時可考慮採用。
流行病學
骨髓浸潤最常見的原因是腫瘤,貧血又是惡性腫瘤的常見症狀,無論有否轉移均可發生,其貧血的發病率約為29.3%~42.98%,骨髓內血運豐富,是癌腫較易血行轉移的組織之一,有時骨髓是首發或惟一的轉移部位,其發生率與病期早晚及腫瘤類型有關。原發病可在乳腺、肺、腎、前列腺、胃肝、結腸、子宮等處,幾乎各種惡性腫瘤均可發生骨髓轉移浸潤造成貧血。但原發癌不明者有時可達20%~40%,有些病例因血液學異常,骨髓檢查首先發現轉移癌細胞而原發腫瘤不明而事後才檢出。
1936年Rohr及Hegglin首先報導75例腫瘤患者胸骨穿刺發現有11例轉移癌此後有陸續報導,Jonsson152例中骨髓轉移癌占47%,Hashimotm等報導260例中骨髓轉移癌占35.2%,57例肉瘤中54.4%有骨髓轉移,其中以淋巴肉瘤及網狀細胞肉瘤轉移率最高Flancis等統計1321例轉移骨髓的原發腫瘤中乳癌占首位(363例)。轉移部位以胸骨最多見順次為脊椎、股骨肱骨轉移幾乎僅見於紅髓。過去認為骨髓轉移一般為晚期腫瘤,有人報導有些腫瘤首先發現骨髓轉移癌以後才確診原發惡性腫瘤,有些腫瘤早期即可發生骨髓轉移,而後發生骨髓進行性貧血的發病率比較高。Jonsson在71例骨髓浸潤中90%血紅蛋白低於正常,Contleras在100例骨髓貧血中,74%呈中度貧血,貧血的程度和病情輕重有關,可見早期明確診斷對防治惡性腫瘤至關重要。
